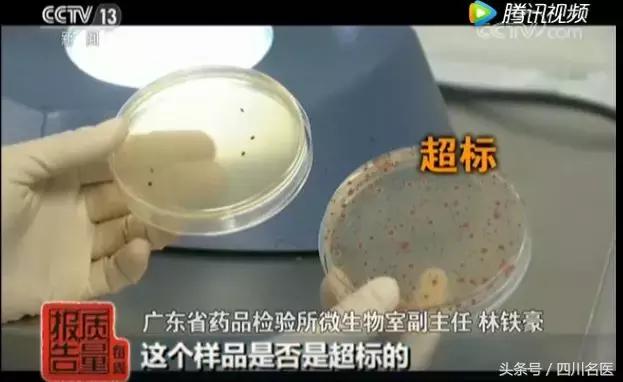
27批次面膜不合格名称,27款不合格面膜名单视频

对于我们精致的猪猪女孩来说:

除了补水外,大家也都对面膜的功效满怀期待——变白、祛痘、去皱纹……
据数据显示,中国消费者对面膜情有独钟,这也导致中国成为了世界上人均面膜消费量第一的国家。
但昨日(9月24日),一个热词却在热搜榜前排挂了大半天——27批次不合格面膜。
(视频来源:《每周质量报告》)
这些面膜含激素
菌落超标7200倍!
据《每周质量报告》节目报道,前段时间(2018年6月25日),国家药品监督管理局对27批次不合格面膜进行了通告。

《每周质量报告》节目记者来到参加这次化妆品监督抽查的权威机构之一广东省药品检验所了解情况。
检测发现,一款由广州博羿化妆品有限公司生产的“茜茜雨露熊果苷雪颜亮肤隐形面膜”,其菌落总数超限量值84倍。
也就是说,这款用于保养美容的面膜,表面看上去洁白干净,实际上布满了菌落。
在菌落总数不合格的面膜样品中,记者注意到,有两批次面膜检验结果超限量值上千倍。一款标称为婴国天使婴儿蚕丝面膜的样品,其菌落总数超出标准限量值1000倍。
还有一款标称为珀微•面膜®蓝莓嫩肤细致面膜,超出标准限量值7200倍。

不合格面膜存在的问题还远不止于菌落超标。一位消费者表示,她在美容院买了一款“膜法奇迹之补养面膜”,用了2盒后,她的脸开始脱屑、发痒。
检测发现这款面膜,导致消费者出现皮肤问题的原因不是菌落总数超标,而是面膜样品非法添加了糖皮质激素。
皮肤科专家介绍,糖皮质激素的短期效果就是可以收缩毛细血管,让脸部发红或肤质敏感的人,皮肤一下子变得好了。
如果长期使用,糖皮质激素会带来许多严重的不良反应,如浮肿、*疮痤**、高血压、高血脂、低血钾、骨质疏松,还可能诱发或加重糖尿病等疾病以及令胎儿畸形等等。
网友炸了,纷纷表示 :


此次被“点名”名单公布
快自查
据国家药品监督管理局官网发布的上述《通告》,涉及的标示代理(生产)企业、不合格产品为:
广州博羿化妆品有限公司生产的茜茜雨露洋甘菊舒缓调理面膜、茜茜雨露熊果苷雪颜亮肤隐形面膜、茜茜雨露备长炭净颜水润黑金面膜和沁颜芯鲜润·复活草瞬透沁润补水面膜;
佛山市南海区里水从容化妆品厂生产的美丽习惯®从容美白面膜和比比兔®备长炭清爽保湿面膜;
广州疆漫生物科技有限公司生产的纤之恋®倍润修护丝滑海藻面膜和纤之恋®雪肌亮肤补水海藻面膜;
广州市缔造美化妆品有限公司(委托方:广州尚雪生物科技有限公司)生产的城市物语®备长炭深层清洁黑膜和城市物语®竹炭纤维保湿紧致面膜;
深圳市天然源科技发展有限公司保健化妆品厂生产的海洋传说补水透白面膜和深海鱼油高倍水润面膜;
广州名颜化妆品有限公司(委托方:广州颜膜生物科技有限公司)生产的婴国天使婴儿蚕丝面膜;
广州市胜梅化妆品有限公司生产的名蔻玻尿酸水漾透亮双层面膜;
广州精挚生物科技有限公司生产的膜法奇迹之补养面膜;
廣州市潔思化妆品制造有限公司生产的佐伊偌螞蟻深層潤白保濕神仙面膜;
广州市尚品汇化妆品有限公司生产的若泉水磁场立润保湿蚕丝面膜;
广州珈芮化妆品有限公司生产的静距离千颜蜜语桃花净颜靓肤面膜;
广州市纤雅化妆品有限公司生产的纤美玻尿酸原液水润赋嫩蚕丝面膜;
广州美珍生物科技有限公司〔委托方:美国凯纳国际(香港)有限公司〕生产的水盈七子白水分缘面膜;
广州市有喜化妆品有限公司生产的珀微·面膜®蓝莓嫩肤细致面膜;
武汉润禾生物医药有限公司生产的维生素E-B嫩肤补水面膜和谷幽兰净白面膜;
*疆新**方冠杨氏化妆品有限公司生产的玉颜面膜一号和玉颜面膜二号;
上海伸庭生物科技有限公司代理的台湾森田保湿精华水嫩面膜。
其中,经生产企业所在地食品药品监督管理部门现场核查,并经生产企业确认:
标示广州名颜化妆品有限公司(委托方:广州颜膜生物科技有限公司)生产的婴国天使婴儿蚕丝面膜;
广州市纤雅化妆品有限公司生产的纤美玻尿酸原液水润赋嫩蚕丝面膜;
广州市有喜化妆品有限公司生产的珀微·面膜®蓝莓嫩肤细致面膜。
等相关批次产品为假冒产品。
快自查,有你用的吗?
面膜怎么选
小康妹儿告诉你
俗话说:面膜敷得好,青春飞不了。

面膜有用,但是护肤效果也比较局限。
它可以用来解决一些皮肤问题的,比如补水、清洁、舒缓等。
但如果想要美白,祛斑、紧致、抗衰老等就不现实了。(整形科的医生不要面子的吗!!!面膜有那么大的作用,这些医生都可以下岗了好伐!!!)
所以,选面膜可以按“三看四不选”的原则:
1
看品名

包装的风格可以千变万化,但能够写在化妆品包装上的字却是必须遵循规章制度的。
化妆品包装上的文字有了更严格的规定。特别是品名,像“美白、提亮、祛斑、除皱、抗衰”等明确功能性的词语除非有特殊备案,否则从现在开始是不允许出现在品名的。
而能得到这些备案的,一般都是具备强大科研能力的大企业。
如果你看到生产厂家是一个广州不知名的小厂,但品名上却有一大堆“违禁词语”,那么这款产品肯定没有通过国家备案,购买时请谨慎。
2
看产品介绍
产品介绍中表示绝对的功效性介绍都是不允许出现的,比如“使用后立即白亮、除皱效果最好、淡斑最快”等等,再好的护肤品也只能循序渐进的保养皮肤,又不是易容术能立马换脸。
所以大家看到这种介绍的时候一定不要冲动,因为一是备案时这种介绍一定不会通过,但厂家拿出来卖就说明一定没通过备案;
二是如果这个产品真有立即白,马上嫩的效果那很有可能就是添加了激素类违禁成分。
3
看渠道
大家一定要通过正规渠道购买化妆品,包括大型百货的品牌专柜及品牌官网网站,记得索取并保留相关单据。
而电商(尤其是微商)、海代、跨境电商等渠道则要慎之又慎。
4
不选有颜色的面膜
很多睡眠面膜都是带有颜色的,有蓝色、橙色、青绿色等。
这些颜色虽然看着令人心情愉悦,但它们是用色素调出来的。只是为了着色和制造不同的宣传卖点,没有任何护理作用。
5
不选添加香精的面膜
如果您的皮肤属于敏感皮肤,选购时更要注意查看产品包装上的成分标示,含香精的产品在成分标示中可见。
6
不选质地格外粘稠的产品

这种产品可能添加了增稠剂。
7
不选残留水分多的面贴膜
不少朋友在使用面贴膜时存在一个误区,以为面贴膜包装袋内残留的水分多就代表该款产品所含精华液多,使用效果更好。
一款优质的面贴膜,不光对配方的安全性、有效性提出更高要求,还要求所用的面贴膜材质的吸水性、锁水性、透气性都要好,而且轻薄、柔软、服贴,能够完美地敷于脸部,质地轻盈,敷脸时面部不会有任何负担、不适地感觉,敷着就像没敷一样。而且绝对不会出现精华液满地洒的现象,其所含的精华液也不会像水一样稀薄。
8
慎用含水杨酸、果酸成分的面膜
这类产品不建议每天使用,也不可以经常使用。
特别是敏感肌肤,因其强酸性更易导致皮肤过敏,角质层变薄,甚至引发接触性皮炎。

不建议每天都做面膜,这属于过度护理行为。面膜属于密集护理,每周二到三次即可。
过度面膜会使皮肤补水过度、角质层油分丢失,角质细胞间的连接松散,变为敏感受损肌肤。
最后提醒大家!
买面膜或者任何护肤品/化妆品
请坚定拒绝朋友圈中的微商和某宝!

(希望大家安全地美美哒OuO)
本文来源:新华网、中国青年报、每日经济新闻
编辑:懒懒
图片来源:123rf、soogif